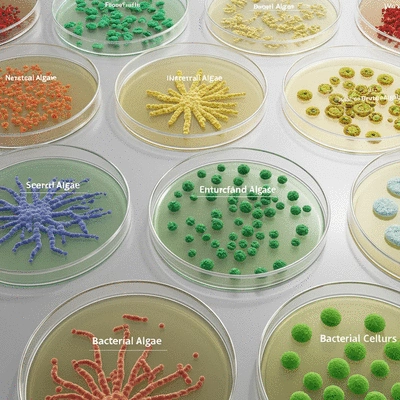
Close-up of a diverse range of beneficial bacterial cultures in petri dishes, labeled for different algal types

Nutrient Competition
What if your pond's health could be significantly improved by harnessing the power of tiny microorganisms? Beneficial bacteria are not just microscopic entities; they play a crucial role in managing algal blooms and maintaining a balanced aquatic ecosystem.
This visual illustrates the multifaceted approach of beneficial bacteria in managing algal blooms, highlighting their mechanisms, environmental benefits, and practical applications compared to chemical treatments.
Nutrient Competition
Algicidal Compounds
Organic Matter Breakdown
Chemical-Free Solution
Protects Aquatic Life
Enhances Water Quality
Correct Dosage Calculation
Regulatory Compliance
Ecotoxicology Evaluation
Managing a pond can feel like a complex puzzle, especially when it comes to tackling algal blooms. Understanding these blooms and the role of beneficial bacteria is crucial for maintaining a healthy aquatic ecosystem. In this section, we'll explore what algal blooms are, their impacts, and how beneficial bacteria can help mitigate these issues.
Algal blooms are rapid increases in the population of algae in a body of water, often resulting in a thick green mat on the surface. These blooms typically occur due to an excess of nutrients, particularly nitrogen and phosphorus, which can originate from fertilizers, runoff, and other sources. Are you noticing a green tint in your pond? That could be a sign of an algal bloom forming!
It's essential to identify the type of algal bloom as well. While some algae are harmless and even beneficial, others can produce toxins harmful to fish and wildlife. Knowing this difference can make a significant impact on how you manage your pond.
Harmful algal blooms (HABs) can lead to severe consequences for water quality and aquatic life. These blooms can deplete oxygen levels in the water, resulting in dead zones where fish and other organisms cannot survive. Additionally, some species of algae produce toxins that can affect not only aquatic life but also pets and humans. Research from sources like mBio, an open-access journal of the American Society for Microbiology, details the mechanisms of how certain bacterial species can inhibit harmful algal bloom-forming cyanobacteria, highlighting the critical impact of these phenomena.
Recognizing the signs of HABs is a key part of maintaining a healthy pond environment. Regular monitoring is essential to catch these blooms before they become a significant problem.
Eutrophication is a natural process that occurs when bodies of water become overly enriched with nutrients, leading to excessive growth of algae. This process can be accelerated by human activities, such as agricultural runoff and urban development. It's important to be aware of how our actions can contribute to this phenomenon, as noted by Oregon State University Extension, which emphasizes that prevention is the best defense against algae blooms.
When we discuss managing algal blooms, understanding eutrophication is vital. By addressing the sources of nutrient pollution, we can help reduce the occurrence of harmful blooms. Are you curious about how to achieve this in your own pond?

Beneficial bacteria play an essential role in controlling algal blooms by outcompeting harmful algae for available nutrients. These bacteria not only thrive in our ponds but also create a balanced environment where algae struggle to survive. Incorporating beneficial bacteria into your pond care routine can lead to significant improvements in water quality.
By introducing these helpful microorganisms, you're promoting a natural ecological balance that can help keep your pond clear and healthy!
Beneficial bacteria use several mechanisms to combat algae. They compete for nutrients, effectively starving harmful algae of the resources they need to flourish. Additionally, some species of beneficial bacteria release compounds that inhibit algal growth, further enhancing their role in algae control. A comprehensive review of biological control of harmful algal blooms, published in PMC, an archive of biomedical and life sciences journal literature, highlights the efficacy of algicidal bacteria in mitigating these blooms.
This natural approach not only helps manage algae but also supports the overall health of your pond.
Bioaugmentation is the process of adding beneficial bacteria to a pond to enhance its natural microbial population. This method can be particularly effective in controlling algal blooms. By boosting the number of beneficial bacteria, you can create a more resilient ecosystem that can withstand algal invasions.
Would you like to explore how bioaugmentation could fit into your pond management strategy? Implementing this practice is a proactive step towards achieving a thriving aquatic environment!
Choosing chemical-free solutions for algae management is not only better for your pond but also for the surrounding environment. Chemical treatments can harm beneficial organisms and disrupt the ecosystem balance. Using beneficial bacteria allows you to maintain a healthy pond without introducing harmful chemicals.
By opting for eco-friendly methods, you're investing in the long-term health of your pond and the environment!
Beneficial bacteria not only help in controlling algae but also support the restoration of seagrass beds, which are vital for a healthy ecosystem. These bacteria enhance nutrient cycling and improve sediment stability, leading to better growth conditions for seagrasses.
By fostering these connections, we can create vibrant aquatic habitats that support diverse plant and animal life. Are you excited to learn how you can contribute to these efforts in your own pond?
The introduction of beneficial bacteria can positively affect the nitrogen and phosphorus cycles within freshwater ecosystems. By breaking down organic matter and converting nutrients into less harmful forms, these bacteria help keep nutrient levels in check.
This natural regulation is crucial for preventing the conditions that lead to harmful algal blooms. Would you like to know more about how to implement these practices in your pond management?
To ensure the effectiveness of beneficial bacteria in managing algae, it's crucial to apply the correct dosage. Factors such as pond size, current algae levels, and water temperature can all influence the necessary amount of bacteria. I recommend consulting a pond care expert to determine the best approach for your situation.
By following these guidelines, you'll set your pond up for success!
Numerous case studies have demonstrated the effectiveness of beneficial bacteria in reducing algal blooms. For instance, a pond in my local area experienced a dramatic reduction in bloom frequency after implementing a bioaugmentation strategy. This real-world example highlights the potential for success!
Understanding documented results can help you feel confident in your choices and inspire you to take action in your pond management.
In aquaculture, beneficial bacteria can be invaluable for maintaining water quality and supporting fish health. By integrating these bacteria into your aquaculture systems, you can help reduce the risk of harmful algal blooms and create a more balanced environment for your fish.
Are you curious about how to apply these principles in your own aquaculture practices? The right approach can make a significant difference!
While beneficial bacteria offer many advantages, there can be challenges in their implementation. Issues such as incorrect dosage, unfavorable environmental conditions, or the presence of competing non-beneficial bacteria can hinder success.
Being aware of these challenges will help you better prepare for your own pond care journey and increase your chances of success.
When introducing any new organisms, it's essential to consider regulatory compliance and safety protocols. Different regions may have specific guidelines regarding the introduction of bacteria into aquatic environments. Always check with local authorities to ensure you're following proper procedures.
Isn't it reassuring to know that prioritizing safety and compliance can lead to better outcomes for your pond?
Understanding the potential ecological impacts of bacterial treatments is crucial. Conducting ecotoxicological assessments can help ensure that the beneficial bacteria you choose are safe for your pond's ecosystem and won't inadvertently harm other organisms.
By making informed decisions, you’re supporting a healthier pond environment and promoting the well-being of all its inhabitants!
Not all beneficial bacteria are created equal! Different strains can target specific types of harmful algae, so it's essential to choose the right one for your pond's unique conditions. Researching and understanding these differences can lead to more effective management strategies.
Are you excited to find out which bacterial strains might be best suited for your pond?
When considering algae management options, it's important to weigh the costs and benefits of using beneficial bacteria versus traditional chemical treatments. While chemical options may provide quick fixes, they often come with long-term consequences. In contrast, beneficial bacteria offer a more sustainable, eco-friendly approach.
Making informed decisions about treatment options is key to achieving a thriving pond!
Lastly, understanding the diversity of bacteria in aquatic environments can enhance your management strategies. Different species contribute to various ecological processes, and recognizing their roles can help you maintain a balanced ecosystem in your pond.
Embracing this diversity is not just about managing algae; it’s about fostering a thriving environment where all organisms can coexist harmoniously!
To effectively manage algal blooms in your pond, consider incorporating a routine of regular water quality testing and introducing beneficial bacteria. This proactive approach not only helps in controlling algae but also enhances the overall health of the aquatic ecosystem. Aim to test your water monthly, and reapply beneficial bacteria every 4-6 weeks during peak growth seasons for optimal results!
Algal blooms are primarily caused by an excess of nutrients, especially nitrogen and phosphorus, often originating from sources like fertilizers and runoff. These nutrient overloads promote rapid algal growth.
HABs can severely deplete oxygen levels in the water, creating "dead zones" harmful to aquatic life. Some HABs also produce toxins that are dangerous to fish, pets, and humans, making the water unsafe for recreation.
Beneficial bacteria suppress algal growth by competing with algae for essential nutrients, effectively starving them. Additionally, some bacterial strains produce algicidal compounds that directly inhibit harmful algae and break down organic matter in the pond.
Bioaugmentation is the process of introducing beneficial bacteria into a pond to boost its natural microbial population. This method enhances the pond's ability to naturally control algal blooms and maintain a balanced ecosystem.
Chemical-free solutions, such as beneficial bacteria, are preferred because they protect aquatic life and the surrounding environment from harmful toxins. They enhance natural water purification processes and contribute to a healthier, more balanced pond ecosystem without disrupting its natural balance.
As we explore the realm of biological algae control, it’s essential to highlight the incredible benefits that beneficial bacteria bring to our aquatic ecosystems. These natural allies not only aid in managing algal blooms but also contribute to the long-term sustainability of our ponds and water environments. By understanding how to effectively implement these solutions, we can ensure healthier ecosystems that thrive for generations to come. Are you ready to dive into the details?
At Clear Pond Solutions, we believe that the future of pond care lies in embracing eco-friendly practices. Biological solutions harness the power of nature and provide a sustainable alternative to chemical treatments. Let’s break down some key aspects as we look forward!
To maintain a thriving aquatic ecosystem, it’s crucial to understand the maintenance requirements and reapplication schedules for beneficial bacteria. While these microorganisms can significantly reduce algal growth, they do need regular monitoring and adjustments. Here are some factors to consider:
By adhering to these guidelines, you can help maintain a balanced ecosystem. The future research directions in algal management are also promising, focusing on enhancing the efficacy of these beneficial strains.
Exciting advancements are on the horizon! Research is continually evolving to find more effective applications of beneficial bacteria. Key areas of focus include:
These areas of research pave the way for more robust and adaptable strategies in managing algal blooms, ensuring that our ponds remain vibrant and healthy.
Microbial ecology plays a fundamental role in the health of aquatic ecosystems. By fostering a diverse microbial community, we can enhance natural processes that support a balanced environment. This approach not only aids in algae management but also contributes to:
Understanding these dynamics helps us appreciate the intricate relationships in pond ecosystems and underscores the importance of maintaining biodiversity.
Now that we've explored the benefits of beneficial bacteria, it’s time to take action! Implementing these solutions can significantly improve your pond’s health and aesthetic. Here are some steps to seamlessly integrate beneficial bacteria into your algae management strategy:
By following these steps, you can effectively manage algal blooms while promoting a thriving aquatic environment.
Community engagement is vital for the long-term success of any sustainable practice. By fostering awareness about the importance of beneficial bacteria, we can encourage more pond owners and caretakers to adopt eco-friendly methods. Consider hosting informational sessions or workshops in your area to:
By working together, we can create a community dedicated to preserving our precious aquatic ecosystems!
Lastly, promoting aquatic biodiversity is crucial for healthy ponds. By implementing effective management strategies that focus on using beneficial bacteria, we can support a rich variety of life. Here are a few ways to enhance biodiversity in your pond:
Ultimately, our goal at Clear Pond Solutions is to empower you with the knowledge and tools to create and maintain clean, healthy pond ecosystems. Are you ready to embrace these sustainable practices and enhance the beauty of your water environment?
Here is a quick recap of the important points discussed in the article:
At Clear Pond Solutions, we empower you with expert guidance and eco-friendly solutions to create and maintain pristine, healthy pond ecosystems. Your thriving pond is our priority.
